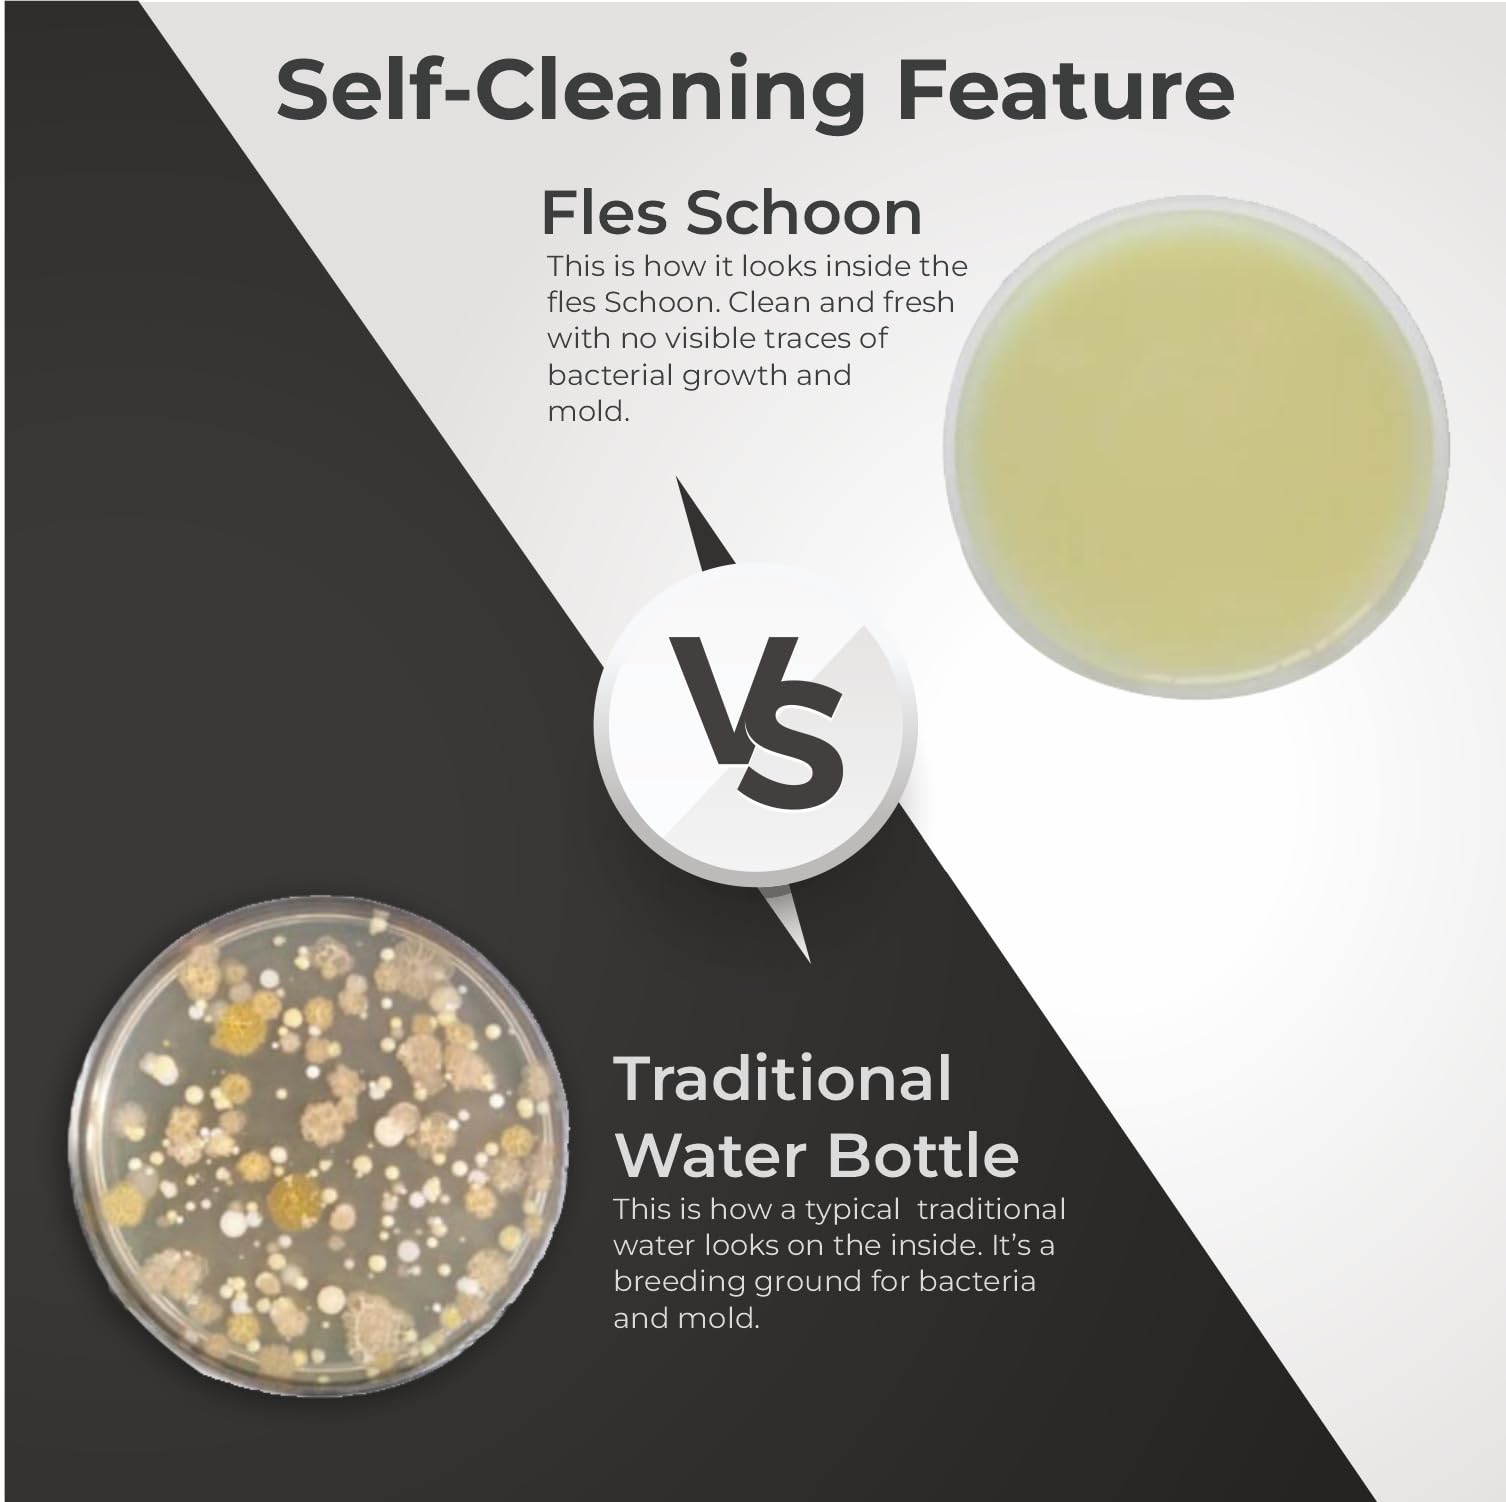
Thumbnail 4

Customer Services
Copyright © 2025 Desertcart Holdings Limited
Desert Online General Trading LLC
Warehouse # 7, 4th Street, Umm Ramool, Dubai, 30183, Dubai

💧 Stay fresh, stay smart — hydration redefined.
The Fles® Schoon is India’s first smart water bottle combining UV-C sterilization technology that kills 99.99% of bacteria and viruses in just 3 minutes, with a 7-layer insulated stainless steel body and a real-time temperature display. Featuring smart hydration reminders and crafted from BPA-free materials, this 500ml bottle is designed for health-conscious professionals who demand purity, style, and convenience in every sip.






| Brand | ecoop |
| Material | Stainless Steel |
| Bottle Type | Stainless-Steel |
| Colour | Blue |
| Capacity | 500 Milliliters |
| Special Feature | Hydration Reminder, Vacuum Insulation, UV-C Water Purification System, Temperature Display |
| Age Range (Description) | Adult |
| Product Dimensions | 25W x 7H Centimeters |
| Model Name | fles Schoon. |
| Recommended Uses For Product | Travel, Sports |
| Number of Items | 1 |
| Reusability | Reusable |
| Shape | Round |
| Material Type Free | Bisphenol A (BPA) Free |
| Finish Type | Stainless Steel |
| Sport | Running |
| Net Quantity | 1.00 Unit |
| Package Information | Bottle |
| Item Weight | 0.55 Kilograms |
| Manufacturer | ecoop |
| Model number | E-FSCHOON |
| Item Weight | 550 g |
| Batteries | 4 Lithium Polymer batteries required. (included) |
| Item model number | E-FSCHOON |
| Included Components | Booklet |
| Are batteries included? | Yes |
| Lithium battery energy content | 12 Watt Hours |
| Lithium Battery Packaging | Batteries contained in equipment |
| External Certification | NABL certified, CE, FDA approved |
J**T
Problems with high intensity UV sterilization
Guys please be careful with such tech, I have got nothing against the company but believe it or not our water sources are getting contimanted day by day with heavy metals and when you sterilizer something with UV for 3 mins, it for sure causes some sort of chemical reactions with heavy metals in water and forms very acidic water, for example UV can react with residual Chlorine to form HCL etc So please be careful!
Trustpilot
2 weeks ago
1 month ago
5 days ago
2 months ago